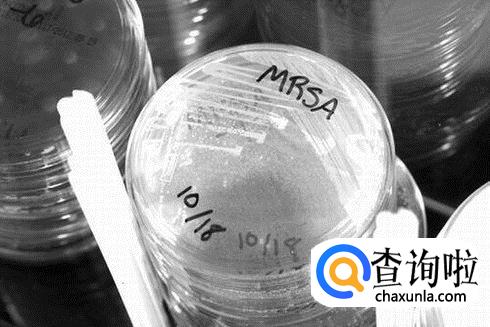

最佳回答
本文由作者推荐
详细内容
- 01
有一种名叫MRSA的“超级细菌”, 这种细菌会引的肺炎,病情会爆发式加重。它会破坏肺结构,也就是传言的把肺“吃”掉。

- 02
感染了MRSA初期,会出现皮肤发红,水肿,疼痛,出现一些小的病疮。

- 03
中期时皮肤上脓疱排出黄色恶臭液体,并伴有发烧,皮肤脓肿,感染周围皮肤区域,

- 04
后期已经比较严重,患者会胸痛(已经感染肺部),打寒战,浑身乏力、头痛发热,有红色皮疹,如不采取急救措施甚至会呼吸困难,昏厥,低血压乃至死亡。

- 05
MRNS很容易造成肺部感染,很不幸的是,它所具有的强大毒性对肺的损伤是不可逆的,所以随着病情的加重,看起来就好像这种超级病毒吧肺“吃掉了”一样。
工具/材料
MRSA“超级细菌”
广告位
点击排行
- 2 排行
- 3 排行
- 4 排行
- 5 排行
- 6 排行
- 7 排行
- 8 排行
- 9 排行
- 10 排行
热点追踪
广告位





















